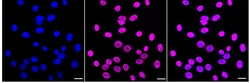
Invitrogen SFPQ Recombinant Rabbit Monoclonal Antibody (24GB1220) 20 &mu;L;

missing translation for 'onlineSavingsMsg'
Learn More
Learn More
Invitrogen™ SFPQ Recombinant Rabbit Monoclonal Antibody (24GB1220)
Rabbit Recombinant Monoclonal Antibody
Brand: Invitrogen™ MA557713
This item is not returnable.
View return policy
Description
SFPQ Recombinant Monoclonal Antibody for Western Blot, ICC/IF, Flow
SFPQ, also named PSF, encodes a nuclear factor implicated in the splicing and regulation of gene expression. SFPQ probably forms a heteromer with NONO and participates in DNA pairing and DNA break repair program. Very recently SFPQ was identified as a downstream target of tau, complete nuclear depletion and cytoplasmic accumulation of SFPQ were shown in the neurons and astrocytes of brains with Alzheimer's disease (AD), more strikingly, reduced SFPQ levels may progress together with tau pathology, these observation strongly suggests the important role of SFPQ pathology in neurodegenerative diseases including AD. SFPQ protein may appears as 47 kDa, 52 kDa or 100 kDa molecules in various cell types.
Specifications
| SFPQ | |
| Recombinant Monoclonal | |
| Unconjugated | |
| SFPQ | |
| 100 kDa DNA-pairing protein; 1110004P21Rik; 2810416M14Rik; 5730453G22Rik; 9030402K04Rik; AU021830; D4Ertd314e; DNA-binding p52/p100 complex, 100 kDa subunit; Gm12940; hPOMp100; NonO/p54nrb homolog; OTTMUSG00000009329; polypyrimidine tract binding protein associated; polypyrimidine tract-binding protein-associated splicing factor; polypyrimidine tract-binding protein-associated-splicing factor; POMP100; PPP1R140; protein phosphatase 1, regulatory subunit 140; PSF; PTB-associated splicing factor; PTB-associated-splicing factor; REP1; Sfpq; splicing factor proline and glutamine rich; splicing factor proline/glutamine rich (polypyrimidine tract binding protein associated); splicing factor proline/glutamine rich (polypyrimidine tract-binding protein-associated); splicing factor proline/glutamine-rich; splicing factor, proline- and glutamine-rich | |
| Rabbit | |
| Affinity Chromatography | |
| RUO | |
| 252855, 6421, 71514 | |
| -20°C | |
| Liquid |
| Flow Cytometry, Western Blot, Immunocytochemistry | |
| 24GB1220 | |
| PBS with 50% glycerol and 0.02% sodium azide; pH 7.4 | |
| P23246, Q8VIJ6 | |
| SFPQ | |
| A synthesized peptide derived from human SFPQ (aa 650-707). | |
| 20 μL | |
| Primary | |
| Human, Mouse, Rat | |
| Antibody | |
| IgG |
Product Content Correction
Your input is important to us. Please complete this form to provide feedback related to the content on this product.
Product Title
Spot an opportunity for improvement?Share a Content Correction